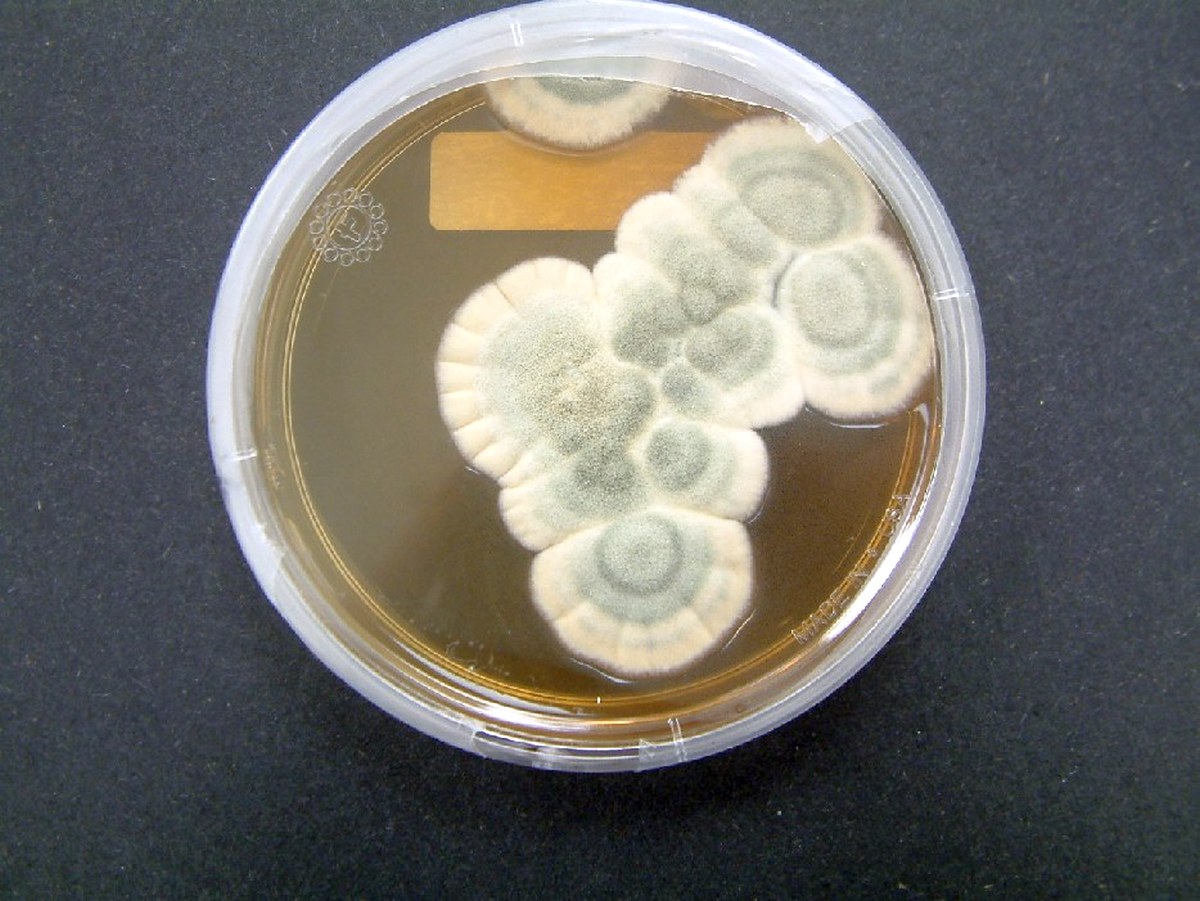
penicillan

Science saves lives!
Last updated: 10 March 2021
You can legally access new medicines, even if they are not approved in your country.
Learn howTop 5 medical breakthroughs from the past, present and future

March for Science in Amsterdam, The Netherlands
Last Saturday we joined millions of people who gathered in over 600 cities worldwide in the March for Science on Earth Day to celebrate science and highlight the huge role that research plays in our everyday life. Many people participated in protest of the Trump administration's policies, which have been widely viewed as being hostile to science, although according to the organisers, the march was a non-partisan movement.
We had many reasons for marching, but as a company that helps seriously ill patients access the latest approved medicines, our primary reason was simple – science saves lives! Without scientists and science research, we’ll never find a cure for diseases like cancer, ALS or Duchenne muscular dystrophy.
Here are the top 5 groundbreaking medical innovations that have either been discovered, are happening now, or are in the pipeline:
1. Penicillin
Image by Crulina 98, via Wikimedia Commons
One of the most well known antibiotics, penicillin was discovered in 1928 when Sir Alexander Fleming accidentally left a petri dish of Staphylococci bacteria uncovered, only to find that the bacteria had been killed by the mould. Thanks to this fortuitous discovery we no longer have to worry about dying from a simple infection; to date, it’s saved an estimated 200 million lives.
2. Insulin

Before insulin was discovered, diabetics would often die at young age. A Nobel prize-winning moment, it’s saved millions of lives and enables a people with diabetes to live normal lives once maintained.
3. Antiviral drugs for HIV and AIDS

Image from Wellcome images
In the 1980s, life expectancy for someone with HIV was about 12 years from the time of infection. Thanks in part to the introduction of Highly Active Antiretroviral Therapy (HAART) in 1996, today an average person infected with HIV in North America can expect to live decades longer, to the age of 63.The treatment saved an estimated 700 000 lives in 2010 alone.
But that’s not all – now the preemptive use of HIV drugs can actually prevent contraction of HIV in the first place, for people who have not yet been exposed to the HIV virus (also known as pre-exposure prophylaxis or PrEP). (We hope to have some exciting news about PrEP very soon...watch this space!)
4. Immunotherapy

Immunotherapy is a new approach to cancer treatment that teaches the body’s defensive immune system to identify cancer cells and attack them from within – in the same way it would fight a cold. Immunotherapy drugs such as Nivolumab have shown promising resultsso far, and have the potential to be an absolute game changer for cancer patients.
5. A genome editing tool to prevent diseases
At first glance this innovation is so extraordinary it almost sounds like science fiction. This gene-editing bio-technology enables scientists to remove or tweak specific parts of one’s DNA, and could hold the potential to prevent cystic fibrosis, polycystic kidney disease, and some breast cancers, by snipping out the defective parts of our genes. Clinical trials for this tool (known as CRISPR) are set to commence this year.
So there you have it – 5 drugs that have changed – or hold the potential to – change the world forever. Who knows how many lives could be saved by drugs that are still in their early stages of development, or have yet to be discovered. One thing’s for sure – as soon as a drug is showing good results and has been approved in well reputed country, we’ll make it our mission to make it available to every patient worldwide as soon as possible – because medicines saves lives!


 Experts in novel medicines
Experts in novel medicines

